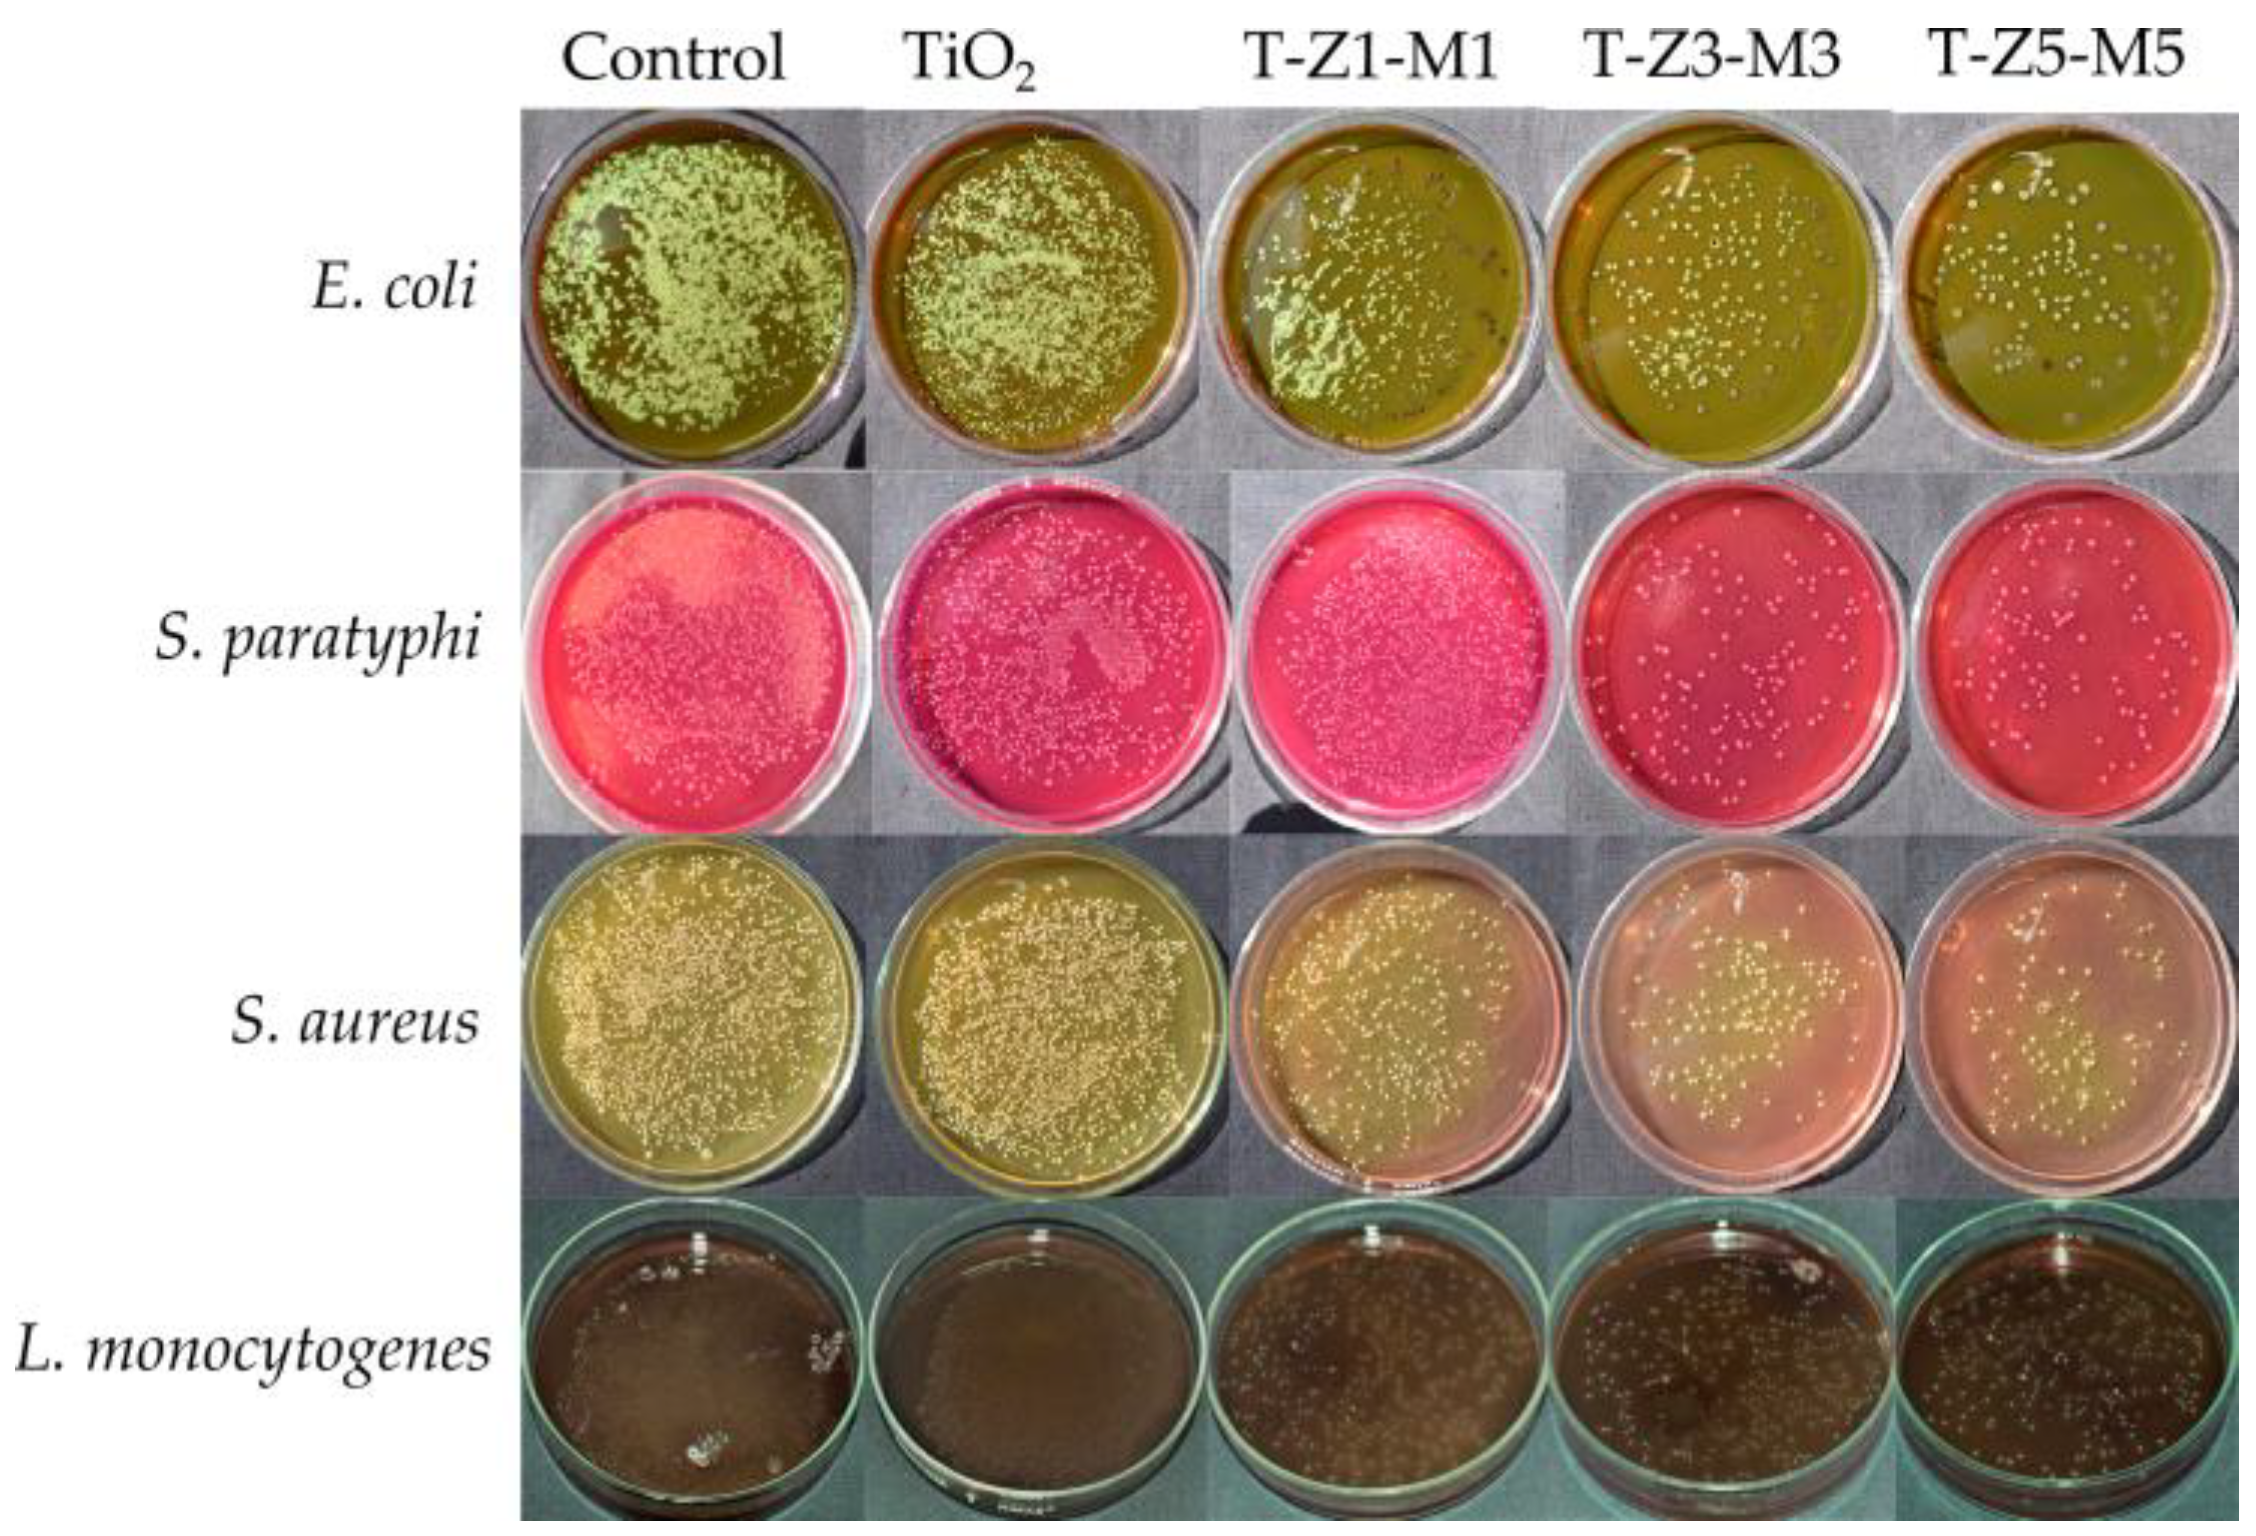
Nanomaterials 09 00992 g005 Nanomaterials 09 00992 g005

Effect of TiO2-ZnO-MgO Mixed Oxide on Microbial Growth and Toxicity against Artemia salina
Abstract
1. Introduction
2. Materials and Methods
2.1. Material Preparation
2.2. Material Characterization
2.3. Bacterial Strains
2.4. Antibacterial Assay
2.4.1. Growth Curve Profiling
2.4.2. Lethal and Sublethal Effect of TiO2-ZnO-MgO Mixed Oxide on Pathogenic Bacteria
2.5. Toxicity Assay
2.6. Data Analysis
3. Results and Discussion
3.1. Transmission Electron Microscopy (TEM) Studies
3.2. Thermal Gravimetric Analysis (TGA-DTGA) and Differential Thermal Analysis (DTA) Curves Analysis of Materials
3.3. Growth Curve Profiling
3.4. Lethal and Sublethal Damage of Mixed Oxide Nanoparticles (MON’s) on Pathogenic Bacteria
3.5. Mortality (%) of Artemia Salina and Toxic Effect (LC50) of Mixed Oxide Nanoparticles (MONs)
4. Conclusions
Author Contributions
Funding
Acknowledgments
Conflicts of Interest
References
- Venkatasubramanian, R.; Srivastava, R.S.; Misra, R.D.K. Comparative study of antimicrobial and photocatalytic activity in titania encapsulated composite nanoparticles with different dopants. Mater. Sci. Technol. 2008, 24, 589–595. [Google Scholar] [CrossRef]
- Sharif, H.A.; Rasha, A.A.E.; Ramia, Z.A.B. Titanium dioxide content in foodstuff from the Jordanian market: Spectrophotometric evaluation of TiO2 nanoparticles. Int. Food Res. J. 2015, 22, 1024–1029. [Google Scholar]
- Pérez-Larios, A.; Hernandez-Gordillo, A.; Morales-Mendoza, G.; Lartundo-Rojas, L.; Mantilla, A.; Gómez, R. Enhancing the H2 evolution from water-methanol solution using Mn2+-Mn+3-Mn4+ redox species of Mn-doped TiO2 sol-gel. Catal. Today 2016, 266, 9–16. [Google Scholar] [CrossRef]
- Robichaud, C.O.; Uyar, A.E.; Darby, M.R.; Zucker, L.G.; Wiesner, M.R. Estimates of upper bounds and trends in nano-TiO2 production as a basis for exposure assessment. Environ. Sci. Technol. 2009, 43, 4227–4233. [Google Scholar] [CrossRef] [PubMed]
- Weir, A.; Westerhoff, P.; Fabricius, L.; Hristtovski, K.; von Goetz, N. Titanium dioxide nanoparticles in food and personal care products. Environ. Sci. Tecnol. 2012, 46, 2242–2250. [Google Scholar] [CrossRef] [PubMed]
- Anaya-Esparza, L.M.; Montalvo-González, E.; González-Silva, N.; Méndez-Robles, M.D.; Romero-Toledo, R.; Yahia, E.M.; Pérez-Larios, A. Synthesis and characterization of TiO2-ZnO-MgO mixed oxide and their antibacterial activity. Materials 2019, 12, 698. [Google Scholar] [CrossRef] [PubMed]
- Kedziola, A.; Strek, W.; Kepinski, L.; Bugla-Ploskonska, G.; Doroszkiewicz, W. Synthesis and antibacterial activity of novel titanium dioxide doped with silver. J. Sol-Gel Sci. Technol. 2012, 62, 79–86. [Google Scholar] [CrossRef]
- Sanmugam, A.; Vikraman, D.; Park, H.J. One-Pot facile methodology to synthesize chitosan-ZnO-graphene oxide hybrid composites for better dye adsorption and antibacterial activity. Nanomaterials 2017, 7, 363. [Google Scholar] [CrossRef]
- Huang, W.; Tang, X.; Wang, Y.; Koltypin, Y.; Gedanken, A. Selective synthesis of anatase and rutile via ultrasound irradiation. Chem. Commun. 2000, 1415–1416. [Google Scholar] [CrossRef]
- Toubal, B.; Bensaha, R.; Yakuphanoglu, F. The influence of copper–cobalt co–doping on optical and electrical properties of nanostructures TiO2 thin films prepared by sol-gel. J. Sol-Gel Sci. Technol. 2017, 82, 478–489. [Google Scholar] [CrossRef]
- Arandiyan, H.R.; Parvari, M. Studies on mixed metal oxides solid solutions as heterogeneous catalysts. Braz. J. Chem. Eng. 2009, 26, 63–74. [Google Scholar] [CrossRef]
- Jesline, A.; Jhon, N.P.; Narayanan, P.M.; Vani, C.; Murugan, S. Antimicrobial activity of zinc and titanium dioxide nanoparticles against biofilm-producing methicillini-resistant Staphyloccus aureus. Appl. Nanosci. 2015, 5, 157–162. [Google Scholar] [CrossRef]
- Liu, N.; Chang, Y.; Feng, Y.; Cheng, Y.; Sun, X.; Jian, H.; Feng, Y.; Li, X.; Zhang, H. {101}−{001} Surface heterojunction-enhanced antibacterial activity of titanium dioxide nanocrystals under sunlight irradiation. ACS Appl. Mater. Interfaces 2017, 9, 5907–5915. [Google Scholar] [CrossRef] [PubMed]
- Pezzi, L.; Pane, A.; Annesi, F.; Losso, M.A.; Guglielmelli, A.; Umeton, C.; De Sio, L. Antimicrobial effects of chemically functionalized and/or photo-heated nanoparticles. Materials 2019, 12, 1078. [Google Scholar] [CrossRef] [PubMed]
- Fu, T.; Shen, Y.G.; Alajmi, Z.; Yang, S.Y.; Sun, J.M.; Zhang, H.M. Sol-gel preparation and properties of Ag-TiO2 films on surface roughened Ti-6Al-4V alloy. Mater. Sci. Technol. 2015, 31, 501–505. [Google Scholar] [CrossRef]
- Li, J.; Xie, B.; Xia, K.; Li, Y.; Han, J.; Zhao, C. Enhanced antibacterial activity of silver doped titanium dioxide/chitosan composite under visible light. Materials 2018, 11, 1403. [Google Scholar] [CrossRef] [PubMed]
- Hassan, M.S.; Amna, T.; Al-Deyab, S.S.; Kim, H.C.; Oh, T.H.; Khil, M.S. Toxicity of Ce2O3/TiO2 composite nanofibers against S. aureus and S. typhimurium: A novel electrospun material for disinfection of food pathogens. Colloids Surf. A Physicochem. Eng. Asp. 2019, 415, 268–273. [Google Scholar] [CrossRef]
- Venkatasubbu, G.D.; Baskar, R.; Anusuya, T.; Seshan, C.A.; Chelliah, R. Toxicity mechanism of titanium dioxide and zinc oxide nanoparticles against food pathogens. Colloids Surf. B Biointerfaces 2016, 148, 600–606. [Google Scholar] [CrossRef] [PubMed]
- Korshed, P.; Li, L.; Liu, Z.; Mironov, A.; Wang, T. Antibacterial mechanisms of a novel type picosecond laser-generated silver-titanium nanoparticles and their toxicity to human cells. Int. J. Nanomed. 2018, 13, 89–101. [Google Scholar] [CrossRef] [PubMed]
- Mu, L.; Sprando, R. Application of nanotechnology in cosmetics. Pharm Res. 2010, 27, 1746–1749. [Google Scholar] [CrossRef] [PubMed]
- United States Environmental Protection Agency (EPA). Methods for Measuring the Acute Toxicity of Effluents and Receiving Waters to Freshwater Andmarine Organisms, 5th ed.; U.S. Environmental Protection Agency Office Water: Chicago, IL, USA, 2002; pp. 1–263. Available online: http://water.epa.gov/scitech/methods/cwa/wet/disk2_index.cfm (accessed on 15 May 2019).
- Kaewklin, P.; Siripatrawan, U.; Suwanagul, A.; Lee, Y.S. Active packaging from chitosan-titanium dioxide nanocomposite film for prolonging storage life of tomato fruit. Int. J. Biol. Macromol. 2018, 112, 523–529. [Google Scholar] [CrossRef] [PubMed]
- Siripatrawan, U.; Kaewklin, P. Fabrication and characterization of chitosan-titanium dioxide nanocomposite film as ethylene scavenging and antimicrobial active food packaging. Food Hidrocoll. 2018, 84, 125–134. [Google Scholar] [CrossRef]
- Ates, M.; Daniels, J.; Arslan, Z.; Farah, I.O. Effects of aqueous suspensions of titanium dioxide nanoparticles on Artemia salina: Assessment of nanoparticles aggregation, accumulation, and toxicity. Environ. Monit. Assess. 2013, 185, 3339–3348. [Google Scholar] [CrossRef] [PubMed]
- Kokkali, V.; Katramados, I.; Newman, J.D. Monitoring the effect of metal ions on the mobility of Artemia salina nauplii. Biosensors 2011, 1, 36–45. [Google Scholar] [CrossRef] [PubMed]
- Mansfield, C.M.; Alloy, M.M.; Hamilton, J.; Verbeck, G.F.; Newton, K.; Klaine, S.J.; Roberts, A.P. Photo-induced toxicity of titanium dioxide nanoparticles to Daphnia magna under natural sunlight. Chemosphere 2015, 120, 206–210. [Google Scholar] [CrossRef] [PubMed]
- Amiano, I.; Vitorica, J.; Zorita, S. Acute toxicity of nanosized TiO2 to Daphnia magna under UV-A irradiation. Environ. Toxicol. Chem. 2012, 31, 2564–2566. [Google Scholar] [CrossRef] [PubMed]
- Marcone, G.P.S.; Oliveira, Á.C.; Almeida, G.; Umbuzeiro, G.A.; Jardim, W.F. Ecotoxicity of TiO2 to Daphnia similis under irradiation. J. Hazard. Mater. 2012, 211–212, 436–442. [Google Scholar] [CrossRef]
- Hund-Rinke, K.; Simon, M. Ecotoxic effect of photocatalytic active nanoparticles (TiO2) on algae and daphnids. Environ. Sci. Pollut. Res. 2006, 13, 225–232. [Google Scholar] [CrossRef]
- Ma, H.; Brennan, A.; Diamond, S.A. Phototoxicity of TiO2 nanoparticles under solar radiation to two aquatic species: Daphnia magna and Japanese medaka. Environ. Toxicol. Chem. 2012, 31, 1621–1629. [Google Scholar] [CrossRef]
- Gambardella, C.; Mesaric, T.; Milivojevic, T.; Sepcic, K.; Gallus, L.; Carbone, S.; Ferrando, S.; Faimali, M. Effects of selected metal oxide nanoparticles on Artemia salina larvae: Evaluation of mortality and behavioural and biochemical responses. Environ. Monit. Assess. 2014, 186, 4249–4259. [Google Scholar] [CrossRef]
- Rekulapally, R.; Murthy Chavali, L.N.; Idris, M.M.; Singh, S. Toxicity of TiO2, SiO2, ZnO, CuO, Au and Ag engineered nanoparticles on hatching and early nauplii of Artemia sp. PeerJ 2019, 6, 6138. [Google Scholar] [CrossRef] [PubMed]
- Ozkan, Y.; Altinok, I.; IIhan, H.; Sokmen, M. Determination of TiO2 and AgTiO2 nanoparticles in Artemia salina: Toxicity, morphological changes, uptake and depuration. Bull. Environ. Contam. Toxicol. 2016, 96, 36–42. [Google Scholar] [CrossRef]
- Cortés, A.A.; Sánches-Fortún, S.; García, M.; Martínez, H.; Bartolomé, M.C. Toxicological assessment of binary mixtures and individually of chemical compounds used in reverse osmosis desalination on Artemia franciscana nauplii. Lat. Am. J. Aquat. Res. 2018, 46, 673–682. [Google Scholar]
- Vidic, J.; Stankic, S.; Haque, F.; Ciric, D.; Le Goffic, R.; Vidy, A.; Jupulle, J.; Delmas, B. Selective antibacterial effects of mixed ZnMgO nanoparticles. J. Nanopart. Res. 2013, 15, 1595. [Google Scholar] [CrossRef] [PubMed]
- Li, X.H.; Xing, Y.G.; Li, W.L.; Jiang, Y.H.; Ding, Y.L. Antibacterial and physical properties of Poly(vynil chloride)-based film coated with ZnO particles. Food Sci. Technol. Int. 2010, 16, 225–228. [Google Scholar] [CrossRef] [PubMed]
- García, D.; Gómez, N.; Mañas, P.; Condón, S.; Raso, J.; Pagán, R. Ocurrence of sublethal injury after pulsed electric fields depending on the microorganism, the treatment medium pH and the intensity of the treatment investigated. J. Appl. Microbiol. 2005, 99, 94–104. [Google Scholar] [CrossRef]
- García, D.; Gómez, S.; Condón, S.; Raso, J.; Pagán, R. Pulsed electric fields cause sublethal injury in Escherichia coli. Letters Appl. Microbiol. 2003, 36, 140–144. [Google Scholar] [CrossRef]
- Masae, M.; Sikong, L.; Sririkun, W. Antibacterial activity of Se doped TiO2 nanoparticles synthesized at low temperature. Romanian J. Mater. 2017, 47, 129–134. [Google Scholar]
- Barbosa, T.P.; Junior, C.G.; Silva, F.P.; Lopes, H.M.; Figueiredo, L.R.; Sousa, S.C.; Vasconcellos, M.L. Improved synthesis of seven aromatic Baylis–Hillman adducts (BHA): Evaluation against Artemia salina Leach and Leishmania chagasi. Eur. J. Med. Chem. 2009, 44, 1726–1730. [Google Scholar] [CrossRef]
- Dhanalakshmi, R.; Pandikumar, A.; Sujatha, K.; Gunasekaran, P. Photocatalytic and antimicrobial activities of functionalized sol-gel embedded ZnO-TiO2 nanocomposite materials. Mater. Express 2013, 3, 291–300. [Google Scholar] [CrossRef]
- Choi, S.K.; Kim, S.; Lim, S.K.; Park, H. Photocatalytic comparison of TiO2 nanoparticles and electrospun TiO2 nanofibers: Effects of mesoporosity and interparticle charge transfer. J. Phys. Chem. 2010, 144, 16475–16480. [Google Scholar]
- Bayal, N.; Jeevanandam, P. Sol-gel synthesis of SnO2-MgO nanoparticles and their photocatalytic activity towards methylene blue degradation. Mater. Res. Bull. 2013, 48, 3790–3799. [Google Scholar] [CrossRef]
- Maurya, A.; Bhatia, N. Microwave assisted sol-gel synthesis of magnesium oxide (MgO). Int. J. Eng. Res. Dev. 2017, 13, 1–6. [Google Scholar]
- Patil, S.; Mali, M.G.; Tamboli, M.S.; Patil, D.R.; Kulkarni, M.V.; Yoon, H.; Kim, H.; Al-Deyab, S.S.; Yoon, S.S.; Kolekar, S.S.; et al. Green approach for hierarchical nanostructured Ag-ZnO and their photocatalytic performance under sunlight. Catal. Today 2016, 260, 126–134. [Google Scholar] [CrossRef]
- Dai, S.; Wu, Y.; Sakai, T.; Du, Z.; Sakai, H.; Abe, M. Preparation of highly crystalline TiO2 nanostructures by acid-assisted hydrothermal treatment of hexagonal-structured nanocrystalline titana/etyltrimethyammonium bromide nanoskeleton. Nanosc. Res. Lett. 2010, 5, 1829–1835. [Google Scholar] [CrossRef] [PubMed]
- Yang, J.; Du, J.; Li, X.; Liu, Y.; Jiang, C.; Qi, W.; Zhang, K.; Gong, C.; Li, R.; Luo, M.; et al. Highly hydrophilic TiO2 nanotubes network by alkaline hydrothermal method for photocatalysis degradation of methyl orange. Nanomaterials 2019, 9, 526. [Google Scholar] [CrossRef]
- Gao, L.; Yin, C.; Luo, Y.; Duan, G. Facile synthesis of the composites of polyaniline and TiO2 nanoparticles using self-assembly method and their application in gas sensing. Nanomaterials 2019, 9, 493. [Google Scholar] [CrossRef]
- Park, E.; Chin, S.; Kim, Y.S.; Bae, G.N.; Jurng, J. One-step synthesis and properties of MnOx/TiO2 nanocomposites by chemical vapor condensation. Powder Technol. 2013, 233, 131–136. [Google Scholar] [CrossRef]
- Vijayalakshmi, R.; Rajendran, V. Synthesis and characterization of nano-TiO2 via different methods. Arch. Appl. Sci. 2012, 4, 1183–1190. [Google Scholar]
- Ghamsari, M.S.; Radiman, S.; Hamid, M.A.A.; Mahshid, S.; Rahmani, S. Room temperature synthesis of highly crystalline TiO2 nanoparticles. Mater. Lett. 2013, 92, 287–290. [Google Scholar] [CrossRef]
- Catauro, M.; Tranquillo, E.; Dal Poggetto, G.; Pasquali, M.; Dell’Era, A.; Vecchio Ciprioti, S. Influence of the heat treatment on the particle size and on the crystalline phase of TiO2 synthetized by the Sol-gel method. Materials 2018, 11, 2364. [Google Scholar] [CrossRef] [PubMed]
- Mahshid, S.; Askari, M.; Ghamsari, M.S.; Afshar, N.; Lahuti, S. Mixed-phase TiO2 nanoparticles preparation using sol–gel method. J. Alloys Compd. 2009, 478, 586–589. [Google Scholar] [CrossRef]
- El-Rady, A.A.A.; El-Sadek, M.S.A.; El-Sayed-Breky, M.M.; Assaf, F.H. Characterization and photocatalytic efficiency of palladium doped-TiO2 nanoparticles. Adv. Nanopar. 2013, 2, 372–377. [Google Scholar] [CrossRef][Green Version]
- Boroica, L.; Radu, D.; Medianu, R.; Vasiliu, I.C.; Boroica, I.S. Properties of glasses from BaO-B2O3-TiO2 system. Romanian J. Mater. 2013, 43, 68–73. [Google Scholar]
- Chen, W.; Nie, H.; Li, D.; Long, X.; Van-Gestel, J.; Maugé, F. Effect of Mg addition on the structure and performance of sulfide Mo/Al2O3 in HDS and HDN reaction. J. Catal. 2016, 344, 420–433. [Google Scholar] [CrossRef]
- Freire, P.L.L.; Albuquerque, A.J.R.; Farias, A.A.P.; Goncalves da Silva, T.; Santos-Aguiar, J.; Galembeck, A.; Flores, M.A.P.; Sampaio, F.C.; Montenegro-Stamford, T.C.; Rosenblatt, A. Antimicrobial and cytotoxicity evaluation of colloidal chitosan–silver nanoparticles–fluoride nanocomposites. Int. J. Biol. Macromoll. 2016, 93, 896–903. [Google Scholar] [CrossRef]
- Sohlenkamp, C.; Galindo-Lagunas, K.A.; Guan, Z.; Vinuesa, P.; Robinson, S.; Thomas-Oates, J.; Raets, C.R.H.; Geiger, O. The lipid Lysil–phosohatydilglycerol is present in membranes of Rhizobium tropici CIAT899 and confers increased resistance to polymyxin B under acidic growth conditions. Mol. Plant Microbe. Interact. 2007, 20, 1421–1430. [Google Scholar] [CrossRef]
- Rajabi, A.; Ghazali, M.J.; Mahmoudi, E.; Baghdadi, A.H.; Mohammad, A.W.; Mustafah, N.M.; Ohnmar, H.; Naicker, A.S. Synthesis, characterization, and antibacterial activity of Ag2O-loaded polyethylene terephthalate fabric via ultrasonic method. Nanomaterials 2019, 9, 450. [Google Scholar] [CrossRef]
- He, P.; Tao, J.; Huang, X.; Xue, J. Preparation and photocatalytic antibacterial property of nitrogen doped TiO2 nanoparticles. J. Sol-Gel Sci. Technol. 2013, 68, 213–218. [Google Scholar] [CrossRef]
- Yamamoto, O. Influence of particle size on the antibacterial activity of zinc oxide. Int. J. Inorg. Mater. 2000, 3, 643–646. [Google Scholar] [CrossRef]
- Leistner, L. Basic aspects of food preservation by hurdle technology. Int. J. Food Microbiol. 2000, 55, 181–186. [Google Scholar] [CrossRef]
- Halpin, R.M.; Duffy, L.; Cregenzan-alberti, O.; Lyng, J.G.; Noci, F. The effect of non-thermal processing technologies on microbial inactivation: An investigation into sub-lethal injury of Escherichia coli and Pseudomonas fluorescens. Food Control. 2014, 41, 106–115. [Google Scholar] [CrossRef]
- Kiang, W.S.; Bhat, R.; Rosma, A.; Cheng, L.H. Effects of thermosonication on the fate of Escherichia coli O157: H7 and Salmonella enteritidis in mango juice. Lett. Appl. Microbiol. 2013, 56, 251–257. [Google Scholar] [CrossRef] [PubMed]
- Ammendolia, M.G.; Losi, F.; De Berardis, B.; Guccione, G.; Superti, F.; Pia Conte, M.; Longhi, C. Listeria monocyogenes behavior in presence of non-irradiated titanium dioxide nanoparticles. PLoS ONE 2014, 9, e84986. [Google Scholar] [CrossRef] [PubMed]
- Chapman, J.S.; Ferguson, R.; Consalo, C.; Bliss, T. Bacteriostatic effect of sequential hydrodynamic and ultrasound-induced stress. J. Appl. Microbiol. 2013, 114, 947–956. [Google Scholar] [CrossRef]
- Khoshnood, R.; Jaafarzadeh, N.; Jamili, S.; Farshchi, P.; Taghavi, L. Acute toxicity of TiO2, CuO and ZnO nanoparticles in brine shrimp, Artemia franciscana. Iranian J. Fish. Sci. 2017, 16, 1287–1296. [Google Scholar]
- Wiench, K.; Wohlleben, W.; Hisgen, V.; Radke, K.; Salinas, E.; Zok, S.; Landsiedel, R. Acute and chronic effects of nano- and non-nano-scale TiO2 and ZnO particles on mobility and reproduction of the freshwater invertebrate Daphnia magna. Chemosphere 2009, 76, 1356–1365. [Google Scholar] [CrossRef]
- Kim, K.T.; Klaine, S.J.; Cho, J.; Kim, S.H.; Kim, S.D. Oxidative stress responses of Daphnia magna exposed to TiO2 nanoparticles according to size fraction. Sci. Total Environ. 2010, 408, 2268–2272. [Google Scholar] [CrossRef]
- Aguilar-Vitorino, H.; Mantovanelli, L.; Pinheiro-Zanotto, F.; Pannia-Espósito, B. Iron metallodrugs: Stability, redox activity and toxicity against Artemia salina. PLoS ONE 2015, 10, e0121997. [Google Scholar]
- Clarkson, C.; Maharaj, V.J.; Crouch, N.R.; Grace, O.M.; Pillay, P.; Matsabisa, M.G.; Bhagwandin, N.; Smith, P.J.; Folb, P.I. In vitro antiplasmodial activity of medicinal plants native to or naturalized in South Africa. J. Ethnopharm. 2004, 92, 177–191. [Google Scholar] [CrossRef]
- Zhu, X.; Chang, Y.; Chen, Y. Toxicity and bioaccumulation of TiO2 nanoparticles aggregates in Daphnia magna. Chemosphere 2010, 78, 209–215. [Google Scholar] [CrossRef]
- Liu, J.; Wang, W.X. The protective roles of TiO2 nanoparticles against UV-B toxicity in Daphnia magna. Sci. Total Environ. 2017, 593, 47–53. [Google Scholar] [CrossRef] [PubMed]
- Cornejo-Garrido, H.; Kibanova, D.; Nieto-Camacho, A.; Guzmàn, J.; Ramirez-Apan, T.; Fernandez-Lomelin, P.; Garduño, M.L.; Cervini-Silva, J. Oxidative stress, cytotoxicity, and cell mortality induced by nano-sized lead in aqueous suspensions. Chemosphere 2011, 84, 1329–1335. [Google Scholar] [CrossRef] [PubMed]
- Zulkifer, A.H.M.D.; Sidiqqua, M.; Nahar, L.; Habib, M.D.R.; Uddin, N.; Hasan, N.; Rana, M.D.S. In vitro antibacterial, antifungal and cytotoxic activity of Scoparia dulcis L. Int. J. Pharm Pharm Sci. 2011, 3, 198–203. [Google Scholar]
- Battinelli, L.; Tita, B.; Evandri, M.G.; Mazzanti, G. Antimicrobial activity of Epilobium spp. extracts. Farmaco 2001, 56, 345–348. [Google Scholar] [CrossRef]
- Zakaria, N.A.; Ibrahim, D.; Sulaiman, S.F.; Supardy, N.A. Assessment of antioxidant activity, total phenolic content and in vitro toxicity of Malaysian red seaweed, Acanthophora spicifera. J. Chem. Pharm. Res. 2011, 3, 182–191. [Google Scholar]
- Halling-Sùrensen, B. Algal toxicity of antibacterial agents used in intensive farming. Chemosphere 2000, 40, 731–739. [Google Scholar] [CrossRef]
- Sánchez, C.; Gupta, M.; de Noriega, Y.M.; Montenegro, G. Bioessay with brine Artemia to predict antibacterial and pharmacologic activity. Rev. Med. Panama 1993, 18, 62–69. [Google Scholar]
- Shriniwas, P.P.; Subhash, T.K. Antioxidant, antibacterial and cytotoxic potential of silver nanoparticles synthesized using terpenes rich extract of Lantana camara L. leaves. Biochem. Biophys. Rep. 2018, 10, 76–81. [Google Scholar]
- Kumar, S.; Selvi, S.; Prabha, A.L.; Selvaraj, M.; Rani, L.M.; Suganthi, P.; Devi, B.S.; Govindaraju, M. Antibacterial activity and in-vitro cytotoxicity assay against brine shrimp using silver nanoparticles synthesized from Sargassum ilicifolium. Dig. J. Nanomater. Biostructures 2012, 7, 1447–1455. [Google Scholar]
- Ullah, M.O.; Haque, M.; Urmi, K.F.; Zulkifer, A.H.M.; Anita, E.S.; Begum, M.; Hamid, K. Anti-bacterial activity and brine shrimp lethality bioassay of methanolic extracts of fourteen different edible vegetables from Bangladesh. Asian Pac. J. Trop. Biomed. 2013, 1, 1–7. [Google Scholar] [CrossRef]
- Ghareeb, M.A.; Hussein, A.H. Antioxidant and cytotoxic activities of Tectona grandis linn. leaves. Int. J. Phytopharm. 2014, 5, 143–157. [Google Scholar]

| Treatment | Reduction Log CFU | ||||
|---|---|---|---|---|---|
| Code | E. coli | S. paratyphi | S. aureus | L. monocytogenes | |
| TiO2 | - | 0.95 ± 0.01 b | 0.66 ± 0.01 c | 0.62 ± 0.04 c | 0.58 ± 0.01 c |
| TiO2–ZnO (1%)–MgO (1%) | T–Z1–M1 | 0.96 ± 0.07 b | 0.90 ± 0.07 b | 0.75 ± 0.02 b | 0.71 ± 0.01 b |
| TiO2–ZnO (3%)–MgO (3%) | T–Z3–M3 | 2.05 ± 0.06 a | 1.94 ± 0.02 a | 1.76 ± 0.01 a | 1.67 ± 0.02 a |
| TiO2–ZnO (5%)–MgO (5%) | T–Z5–M5 | 2.10 ± 0.07 a | 1.87 ± 0.02 a | 1.72 ± 0.01 a | 1.63 ± 0.02 a |
| Concentration (mg/L) | Treatment/Mortality (%) | |||
|---|---|---|---|---|
| TiO2 | T-Z1-M1 | T-Z3-M3 | T-Z5-M5 | |
| 0 | 0 | 0 | 0 | 0 |
| 25 | 3.33 ± 0.57 d | 0 | 0 | 0 |
| 50 | 13.34 ± 0.57 c | 6.67 ± 0.57 c | 3.34 ± 0.57 c | 0 |
| 100 | 20.00 ± 1.00 b | 26.66 ± 0.57 b | 16.34 ± 0.57 b | 10.00 ± 0.01 b |
| 200 | 73.34 ± 0.57 a | 50.00 ± 0.01 a | 30.00 ± 0.01 a | 30.00 ± 0.01 a |
| Treatment | Lethal Concentration (mg/L) | Clarkson’s Toxicity Index | |
|---|---|---|---|
| Range (mg/L) | Results | ||
| TiO2 | 140.36 ± 11.90 d | <100, toxic | Medium toxicity |
| T–Z1–M1 | 238.08 ± 29.62 c | 100–500, medium toxic | Medium toxicity |
| T–Z3–M3 | 891.11 ± 42.26 b | 500–1000, low toxic | Low toxicity |
| T–Z5–M5 | 1468.18 ± 10.05 a | >1000, non-toxic | Non-toxicity |
© 2019 by the authors. Licensee MDPI, Basel, Switzerland. This article is an open access article distributed under the terms and conditions of the Creative Commons Attribution (CC BY) license (http://creativecommons.org/licenses/by/4.0/).
Share and Cite
Anaya-Esparza, L.M.; González-Silva, N.; Yahia, E.M.; González-Vargas, O.A.; Montalvo-González, E.; Pérez-Larios, A. Effect of TiO2-ZnO-MgO Mixed Oxide on Microbial Growth and Toxicity against Artemia salina. Nanomaterials 2019, 9, 992. https://doi.org/10.3390/nano9070992
Anaya-Esparza LM, González-Silva N, Yahia EM, González-Vargas OA, Montalvo-González E, Pérez-Larios A. Effect of TiO2-ZnO-MgO Mixed Oxide on Microbial Growth and Toxicity against Artemia salina. Nanomaterials. 2019; 9(7):992. https://doi.org/10.3390/nano9070992
Chicago/Turabian StyleAnaya-Esparza, Luis M., Napoleón González-Silva, Elhadi M. Yahia, O. A. González-Vargas, Efigenia Montalvo-González, and Alejandro Pérez-Larios. 2019. "Effect of TiO2-ZnO-MgO Mixed Oxide on Microbial Growth and Toxicity against Artemia salina" Nanomaterials 9, no. 7: 992. https://doi.org/10.3390/nano9070992
APA StyleAnaya-Esparza, L. M., González-Silva, N., Yahia, E. M., González-Vargas, O. A., Montalvo-González, E., & Pérez-Larios, A. (2019). Effect of TiO2-ZnO-MgO Mixed Oxide on Microbial Growth and Toxicity against Artemia salina. Nanomaterials, 9(7), 992. https://doi.org/10.3390/nano9070992

